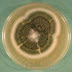

The term chromosome was introduced by waldeyer in 1888. The identification of chromosomes as vehicles of hereditary was put forth by Sutton, boven and others in 1903 - chromosome theory of hereditary. The chromosomes are seen as microscopic thread-like structures in the nucleus of eukaryotes and in the nucleotide region of prokaryotes.
Prokaryotic chromosome
Prokaryotic cell contains neither a distinct membrane around nucleus nor a mitotic apparatus. The Prokaryotic chromosome, almost always a single circle of double stranded DNA is located in an irregularly shaped region called the nucleoid (also called the nuclear body, chromatin body, nuclear region). The nucleoid can be observed under the electron microscope and also under the light microscope after staining with the Feulgen stain, which specifically reacts with DNA. A cell can have more than one nucleoid when cell division occurs after DNA replication. Some bacteria like Agrobacterium tumefaciens are found to have more than 4 chromosomes.
Sinorhizobium meliloti is found to have 3 chromosomes. But usually, most prokaryotes are haploid with only a single chromosome.
In actively growing bacteria, the nucleoid has projections that extend into the cytoplasmic matrix. These may contain DNA that is being actively transcribed to produce mRNA.
Electron microscopic studies have shown the nucleoid in contact with either the mesosome or the plasma membrane which maybe involved in separation of DNA into daughter cells during division. Chemical analysis of nucleoids reveals that they are composed of about 60% DNA, some RNA and a small amount of protein.
In E.coli, a rod shaped bacterium of about 2-6
Recently electron microscope observations have shown the presence of nucleosome-like structure in the E.coli chromosome. DNA is found to constitute 80% by weight of the chromosome and in addition proteins (10% largely RNA polymerase enzyme) and RNA (30% newly transcribed mRNA, tRNA, rRNA) core is present which acts as a scaffold and holds the loops and determines their position. The chromosome appears to be a highly regular. Then negative charge of the DNA neutralized by polyamines such as spermine and spermidine and by Mg2+ as well as basic proteins. A dense region containing membranous material is seen in the central part and is likely to represent fragments of plasma membrane,(mesosomes), to which the chromosomes is attached in the intact cell. The DNA has in addition to the four usual bases small amounts of methylated bases such as 6-methylaminopurine and 5-methylcytosine.
In archaeobecteria like Thermoplasma acidophilus, DNA is found condensed by wrapping around a proteinaceous core, quite unusual for a prokaryote. It contains a single, small, basic histone-like protein (termed HTa) that forms nucleosome like structure containing a core of four molecules of HTa around which a 40 base pair length DNA is wrapped.

 Posted in:
Posted in:

0 comments:
Post a Comment